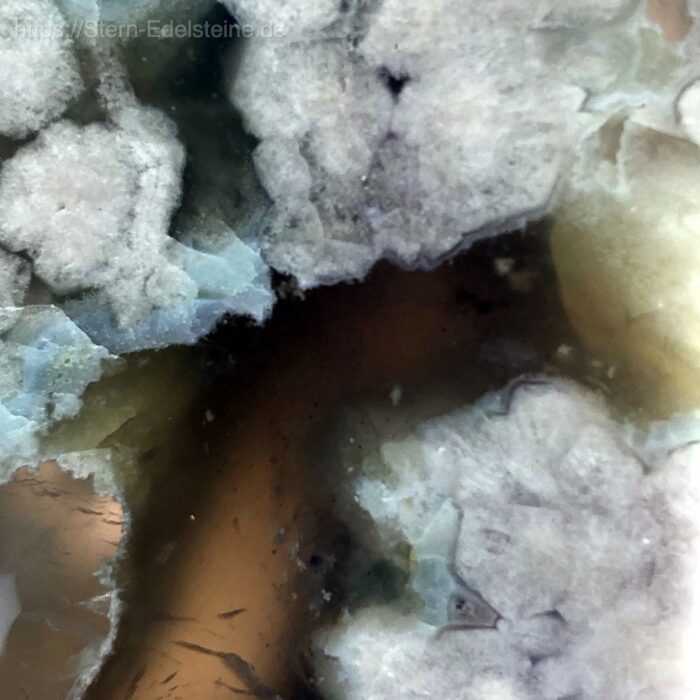
freiformen-Blumenacht-3 Freiformen - Blumenacht – Bild 3

Freiformen – Blumenacht
45,00 €
inkl. 19 % MwSt. zzgl. Versandkosten
Nur noch 1 vorrätig
Ich bin der Blumenachat und kann ich dir helfen, dein volles Potenzial zu entdecken, zu manifestieren und dann dabei enorm in deine Größe zu wachsen. Ich kann dich dabei unterstützen, deine Träume zu verwirklichen, aufzublühen und deinen ganz eigenen Weg zu finden und ihn dann auch zu gehen. Auch wird mir eine starke Verbindung zu deiner femininen Seite nachgesagt, um dich wieder leichter mit deiner Intuition und deinen wahren Gefühlen und Wünschen in Verbindung zu bringen. Ich komme aus Madagaskar.
Themen: Selbstbewusstsein, Heilung, Lebensfreude, Intuition, Kreativität
Physisch: Linderung bei Depressionen helfen, reguliert Erschöpfung und Müdigkeit
Sternzeichen: Sier, Steinbock
Meditation und Chakra: Halschakra, Wurzelchakra
Sollte einmal pro Monat unter fließendem lauwarmem Wasser entladen und über Nacht mit einem Bergkristall aufgeladen werden.
Die Energie der Kristalle ist bis heute leider noch nicht wissenschaftlich erwiesen und
verspricht daher offiziell noch keine Heilwirkung ist aber durchaus mit dem Herzen,
über dein eigenes gutes Gefühl, für dich wahrnehmbar.
Stern Edelsteine
| Gewicht | 0,103 kg |
|---|---|
| Mineral | |
| Chakra | , |
| Sternzeichen | , |
| Themenbereich | , , , , , |
| Marke |